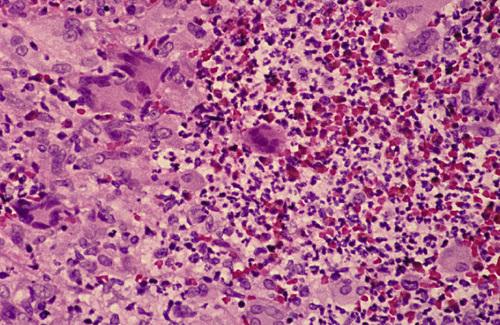

Clinical Features
- localized variant
- involve one to several fungiform papillae
- mildly painful, elevated, red-yellow papules
- occur on anterior dorsal surface of tongue
- generalized variant
- involves many fungiform papillae
- sensitive, enlarged, erythematous
- occur on tip and lateral dorsal surface of tongue
- papulokeratotic variant
- diffuse involvement of fungiform papillae
- asymptomatic, parakeratotic white-yellow papules
- occur on tip and lateral dorsal surface of tongue
Histopathologic Features
- focal areas of exocytosis or ulceration
- proliferation of small vascular channels
- mixed inflammatory cellular infiltrate
- hyperparakeratosis with bacterial colonization
transient lingual papillitis

Tender, yellow-pink papule on the dorsum of the tongue.
transient lingual papillitis, localized

Multiple painful white papules on the lateral dorsum and tip of tongue.
transient lingual papillitis, generalized

Clusters of asymptomatic, elevated, yellow papules on the dorsolateral surface of the tongue.
transient lingual papillitis, papulokeratotic
What is the treatment and prognosis for transient lingual papillitis?
- resolves without therapy
- topical corticosteroids or anesthetics may be used to reduce pain or duration
Clinical Features
- one of the most common oral mucosal pathoses (20%)
- T cell–mediated immunologic reaction with production TNF-α
- appear to be initiated by some antigenic stimulus
- may be associated with systemic disorders
- three clinical variations: mild, moderate, herpetaform
- occur most in children and young adults (80% before 30 years)
Histopathological Features
- central zone of ulceration covered by fibrinopurulent membrane
- increased vascularity of connective tissue
- mixed inflammatory cellular infiltrate
recurrent aphthous stomatitis
Clinical Features
- fewest recurrences and shortest duration
- arise on nonkeratinized mucosa, especially buccal and labial
- yellow-white, fibrinopurulent membrane with erythematous halo
- between 3 and 10 mm in diameter
- heal in 7 to 14 days without scarring
- one to five lesions at a time
- disproportionately painful
minor aphthous ulceration
Clinical Features
- largest lesions and longest duration
- measure 1 to 3 cm in diameter
- yellow-white ulceration with red halo
- take from 2 to 6 weeks to heal and may cause scarring
- occur most on labial mucosa, soft palate, tonsillar fauces
- onset after puberty
major aphthous ulceration
Clinical Features
- greatest number of lesions and most frequent recurrences
- measure 1 to 3 mm in diameter
- up to a hundred present at once
- superficial resemblance to primary HSV infection
- may coalesce into larger irregular ulcerations
- heal within 7 to 10 days
- occur on nonkeratinized, movable mucosa
- female predominance, with onset in adulthood
herpetiform aphthous ulceration

Erythematous halo encircling a yellowish ulceration of the soft palate on the left side.
minor aphthous ulceration

Two ulcerations of different sizes located on the maxillary labial mucosa.
minor aphthous ulceration

Single ulceration of the anterior buccal mucosa.
minor aphthous ulceration

Large, deep, and irregular ulceration of the posterior buccal mucosa. Note extensive scarring of the anterior buccal mucosa from previous ulcerations.
major aphthous ulceration

Large, irregular ulceration of the soft palate.
major aphthous ulceration

Numerous pinhead ulcerations of the ventral surface of the tongue, several of which have coalesced into larger, more irregular areas of ulceration.
herpetiform aphthous ulceration
Aphthous ulcerations that heal within 1 to 2 weeks and recur infrequently.
simple aphthosis
Aphthous ulcerations that occur in multiples and develop continuously.
complex aphthosis
How is recurrent aphthous stomatitis diagnosed?
No laboratory procedure provides definitive diagnosis; the diagnosis is made from the clinical presentation and from exclusion of other diseases.
What is the treatment and prognosis for recurrent aphthous stomatitis?
- topical corticosteroids (e.g. dexamethasone, fluocinonide) for mild disease
- potent corticosteroids (e.g. triamcinolone, clobetasol) for major disease
- in resistant cases, systemic corticosteroids may be required for control
- complex aphthosis demands thorough evaluation for systemic disease

- Large ulceration of the left anterior buccal mucosa.
- Same lesion after 5 days of therapy with betamethasone syrup used in a swish-and-swallow method. The patient was free of pain by the second day of therapy. The ulceration healed completely during the next week.
major aphthous ulceration
Clinical Features
- chronic ocular inflammation and orogenital ulcerations
- systemic vasculitis caused by an abnormal immune process
- usually arises in the third and fourth decades
- increased prevalence and worse clinical course in men
- oral lesions similar to aphthous ulcers often herald onset
- genital lesions (papules, vesicles, pustules, etc.) in 75% of cases
- positive skin “pathergy”
- self-limiting and nondeforming arthritis
- ocular involvement (uveitis, conjunctivitis, etc.) in 70% of cases
- vascular disease often presents as thrombophlebitis
- variable gastrointestinal disease (pain, anorexia, diarrhea, etc.)
- CNS involvement (paralysis, dementia) in 10% to 25% of cases
Histopathological Features
- leukocytoclastic vasculitis
- similar to aphthous stomatitis
Behçet syndrome

Diffuse erythema surrounding numerous irregular ulcerations of the soft palate. Oral ulcerations often herald the onset of this disease.
Behçet syndrome

Numerous irregular ulcerations of the labia majora and perineum as part of a disease characterized by chronic ocular inflammation and orogenital ulcerations.
Behçet syndrome

Sterile pustule of the skin that developed 1 day after injection of saline. This reaction is termed cutaneous pathergy.
Behçet syndrome
From a diagnostic standpoint, one of the most important skin manifestations in Behçet syndrome is the presence of positive “pathergy.” What does this refer to?
One or 2 days after the oblique insertion of a needle under sterile conditions, a tuberculin-like skin reaction or sterile pustule develops.
No laboratory finding is diagnostic of Behçet syndrome. What In an attempt to standardize diagnoses, five definitive criteria have been developed. What are they?
- recurrent oral ulceration, plus and two of the following:
- recurrent genital ulcerations
- eye lesions
- skin lesions
- positive pathergy test
What is the treatment and prognosis for Behçet syndrome?
- most treatment is symptomatic until the disease goes into remission
- old or female patients have a better prognosis than male or young
- ocular lesions or CNS involvement mandate more aggressive therapy
- systemic medications include azathioprine, colchicine, corticosteroids
- orogenital ulcerations respond to topical or intralesional corticosteroids
- relapsing and remitting pattern, with attacks lessening after 5 to 7 years
Clinical Features
- arises prior to age 50, with predilection for females and blacks
- acute cases exhibit fever, fatigue, anorexia, or weight loss
- chronic cases exhibit pulmonary symptoms
- affects lungs, lymph nodes, skin, eyes, and salivary glands
- chronic, violaceous, indurated skin lesions ("lupus pernio")
- scattered, tender erythematous nodules ("erythema nodosum")
- ocular involvement (25%) often appears as anterior uveitis
- salivary gland involvement results in enlargement and xerostomia
- submucosal masses, isolated papules, granularity, or ulcerations
- occur on buccal mucosa, gingiva, lips, tongue, and palate
Histopathological Features
- granulomatous inflammation
- aggregates of epithelioid histiocytes
- surrounding rim of lymphocytes
- scattered Langhans' or foreign body type giant cells
- laminated, basophilic, calcified lysosomes ("Schaumann bodies")
- stellate inclusions of trapped collegen ("asteroid bodies")
sarcoidosis

Violaceous indurated plaques of the right malar area and bridge of nose.
lupus pernio (sarcoidosis)

Multiple erythematous macules of the hard palate. Oral lesions are uncommon in this disease, but may be normal in color, brown-red, violaceous, or hyperkeratotic.
sarcoidosis

Erythematous macules with central hyperkeratosis of the lower labial mucosa. Oral lesions are uncommon in this disease.
sarcoidosis

Labial minor salivary gland demonstrating granulomatous inflammation characterized by circumscribed collections of histiocytes, lymphocytes, and multinucleated giant cells.
sarcoidosis

Multinucleated giant cell with intracytoplasmic asteroid body, a stellate inclusion consisting of entrapped fragments of collagen.
sarcoidosis
A clinical syndrome associated with acute sarcoidosis consisting of erythema nodosum, bilateral hilar lymphadenopathy, and arthralgia.
Löfgren syndrome
A clinical syndrome associated with acute sarcoidosis consisting of parotid enlargement, anterior uveitis of the eye, facial paralysis, and fever.
Heerfordt syndrome (uveoparotid fever)
How is sarcoidosis diagnosed?
- The diagnosis is established by clinical and radiographic presentations, the histopathologic appearance, and negative tests for casative organisms.
- Elevated serum angiotensin-converting enzyme (ACE) levels supports the diagnosis, but is reported in only 60% of patients with the disease.
- In the past, the Kveim test, was performed by intradermal injection of a sterilized suspension of human sarcoid tissue.
What is the treatment and prognosis for sarcoidosis?
- symptoms may resolve spontaneously within 2 years (60%)
- intervention is recommended for progressive disease
- corticosteroids remain first-line therapy
- resistance and relapses are common
- resolution may not occur even with treatment (10% to 20%)
- patients may die of pulmonary, cardiac, or CNS complications (4% to 10%)
Clinical Features
- primarily affects adults, but can occur at any age
- nontender, persistent swelling involving lips
- may be combined with facial paralysis and fissured tongue
- intraoral lesions including edema, ulcers, and papules
- tongue may develop fissures, edema, paresthesia, or erosions
- gingiva can develop swelling, erythema, or pain
- buccal mucosa often exhibits a cobblestone
- linear hyperplastic folds may occur in the sulcus
Histopathological Features
- edema in superficial lamina propria
- dilation of lymphatic vessels
- scattered lymphocytes
- fibrosis in long-term lesions
- noncaseating granulomatous inflammation
- granulomas clustered around scattered vessels
orofacial granulomatosis
The variant of orofacial granulomatosis in which there is nontender, persistent swelling of the lips combined with facial paralysis and a fissured tongue.
Melkersson-Rosenthal syndrome
The variant of orofacial granulomatosis in which there is nontender, persistent swelling of the lips in isolation.
cheilitis granulomatosa (of Miescher)

Nontender, persistent enlargement of the upper lip. This patient did not present with facial paralysis nor a fissured tongue.
cheilitis granulomatosa (orofacial granulomatosis)

Persistent enlargement of the lower lip. This patient also presented with numerous furrows on the dorsal surface of the tongue.
Melkersson-Rosenthal syndrome (orofacial granulomatosis)

Note numerous furrows on the dorsal surface of the tongue. This patient also presented with persistent enlargement of the lower lip.
Melkersson-Rosenthal syndrome (orofacial granulomatosis)

Hyperplastic mucosa noted bilaterally in the mandibular mucobuccal fold with elongated ulcerations in the base of these folds.
orofacial granulomatosis

Clusters of granulomatous inflammation around scattered vessels. The inset illustrates the histiocytes and multinucleated giant cells within the granulomas.
orofacial granulomatosis
How is orofacial granulomatosis diagnosed?
Based on histopathologic demonstration of granulomatous inflammation that is associated with negative special stains for organisms and no foreign material.
What is the treatment and prognosis for orofacial granulomatosis?
- first goal of management is discovery of initiating cause
- intralesional delayed-release high-concentrate triamcinolone
- prognosis is highly variable; some lesions resolve spontaneously

- Diffuse enlargement of the upper lip.
- Same patient after intralesional triamcinolone injections.
orofacial granulomatosis

- Clinical appearance before local therapy.
- Significant resolution after intralesional corticosteroid therapy.
orofacial granulomatosis
Clinical Features
- wide age range (mean, 41 years), 90% in Caucasians
- necrotizing granulomatous lesions of respiratory tract (limited)
- may also exhibit necrotizing glomerulonephritis (generalized)
- may exhibit lesions of the skin and mucosa (superficial)
- nasal drainage, sinus pain, nasal ulceration (URT involvement)
- dry cough, hemoptysis, dyspnea, chest pain (LRT involvement)
- proteinuria and red blood cell casts (renal involvement)
- florid and granular ginvival hyperplasia ("strawberry gingivitis")
- oral ulcerations (usually diagnosed at a later stage)
- salivary gland enlargement
Histopathological Features
- mixed inflammation centered around blood vessels
- heavy neutrophilic infiltration, necrosis, and nuclear dust
- inflammatory cellular infiltrate
- pseudoepitheliomatous hyperplasia and subepithelial abscesses
- prominent vascularity with extensive red blood cell extravasation
Wegener granulomatosis

Florid and granular gingival hyperplasia with hemorrhagic and friable bulbous projections ("strawberry gingivitis").
Wegener granulomatosis

Hyperplastic and hemorrhagic mucosa of the facial mandibular gingiva on the left side. This red, bumpy surface is responsible for the strawberry-like appearance
Wegener granulomatosis

Deep, irregular ulceration of the hard palate on the left side. These represent late-stage disease; more than 60% of patients will have renal involvement.
Wegener granulomatosis
Connective tissue containing proliferation of numerous vascular channels and a heavy inflammatory infiltrate consisting of lymphocytes, neutrophils, eosinophils, and multinucleated giant cells.
Wegener granulomatosis

Gingival biopsy specimen showing a mixed inflammatory cellular infiltrate obscured by extensive extravasation of red blood cells.
Wegener granulomatosis
The American College of Rheumatology proposed four diagnostic criteria with a minimum of two required for a diagnosis of Wegener granulomatosis. What are these criteria?
- oral ulcerations or nasal discharge
- nodules, fixed infiltrates, or cavities on chest radiograph
- abnormal urinary sediment (e.g. RBCs or casts
- granulomatous inflammation upon biopsy
What marker is the most useful in the diagnosis of Wegener granulomatosis, seen in 90% to 95% of generalized cases and 60% of the early or localized cases?
antibodies against proteinase-3 (PR3-ANCA)
What is the treatment and prognosis for Wegener granulomatosis?
- mean survival of untreated patients with generalized disease is 5 months
- 80% of the patients are dead at 1 year and 90% within 2 years
- prognosis is better for the limited and superficial forms
- first line therapy is oral prednisone and cyclophosphamide
- prolonged remission is noted in up to 75% of affected patients
- for maintenance, cyclophosphamide may be replaced with methotrexate
- relapse rate up to 30%, maintenance therapy is necessary in many patients
The risk of an adverse reaction is approximately ___% with the use of two medications, ___% with five drugs, and almost ___% with eight or more.
6%, 50%, 100%
What is a Type A drug reaction?
An exaggerated but otherwise expected pharmacologic action of the prescribed medication (e.g. bleeding associated with warfarin).
What is a Type B drug reaction?
An idiosyncratic reaction that is not expected, usually arising from immune-mediated effects (e.g. hypersensitivity reactions).
A reaction of the oral mucosa to the systemic administration of a medication.
stomatitis medicamentosa
Several different patterns of stomatitis medicamentosa exist. What are the seven classes of mucosal reactions to systemic drug administration?
- anaphylactic stomatitis
- intraoral fixed drug eruptions
- lichenoid drug reactions
- pemphigoid-like drug reactions
- pemphigus-like drug reactions
- lupus erythematosus–like eruptions
- nonspecific erosive, ulcerative, or aphthous-like lesions
Clinical Features
- various patterns of mucosal alterations
- erythema or aphthous-like ulcerations
- localized areas of erythema and edema
- vesiculoerosive lesions of the labial mucosa
- lupus-, pemphigoid-, or pemphigus-like lesions
- bilateral and symmetrical lesions are common
Histopathological Features
- nonspecific pattern of subacute mucositis
- mixed inflammatory cellular infiltrate
- spongiosis and exocytosis of the epithelium
- lupus-, pemphigoid-, or pemphigus-like findings
- DIF for IgG shows annular pattern along basal cell layer ("sting of pearls")
- may detect circulating antibody ("basal cell cytoplasmic antibody")
mucosal reactions to systemic drug administration

- Bilateral erosions of lower labial mucosa with intermixed striae. Biopsy revealed lichenoid pattern of mucositis but with numerous plasma cells intermixed with the lymphocytes.
- Same patient depicted in A after discontinuation of simvastatin.
allergic mucosal reaction to systemic drug administration

Irregular area of superficial erosion of the left buccal mucosa. Lesions were also present on the contralateral buccal mucosa and bilaterally on the lateral borders of the tongue. Lesions disappeared after discontinuing allopurinol.
lichenoid drug reaction

Large irregular erosion of the right ventral surface of the tongue. The lesion arose secondary to use of oxaprozin, a nonsteroidal antiinflammatory drug (NSAID).
allergic mucosal reaction to systemic drug administration
How are mucosal reactions to systemic drug administration diagnosed?
- identify potentially offending medication through detailed
medical history and establish a temporal relationship with the
mucosal alteration
- if more than one suspected, start with most recently added
- if last-introduced drug is not responsible, do serial elimination
- definitive diagnosis can be made if mucosal alterations resolve after discontinuation of medication and recur on reintroduction
- presumptive diagnosis usually is sufficient and justified when the mucosal alterations clear after cessation of the offending medication
- for lupus-like reactions, consider serum evaluation for ANAs dsDNA Ab
What is the treatment for mucosal reactions to systemic drug administration?
- discontinue and replace causative drug and if possible
- lesions can be resolved with topical corticosteroids
- If discontinuation is contraindicated, palliative care can be provided
Clinical Features
- can be acute or chronic
- distinct female predominance
- can be localized or diffuse
- burning is the most frequent symptom
- mucosa may be barely red to brilliantly erythematous
- superficial ulcerations occasionally arise
- muscosa may be white and hyperkeratotic
- desquamation of the superficial layers of the epithelium
- dryness, scaling, fissuring, or cracking of the vermilion border
allergic contact stomatitis

Mucosal erythema and vesicles of the lower labial mucosa caused by use of aluminum chloride on gingival retraction cord.
allergic contact stomatitis

Erythematous mucosa with superficial epithelial desquamation. This patient reported recently changing brands of toothepaste.
allergic contact stomatitis
How is allergic contact stomatitis diagnosed?
- diagnosis of acute contact stomatitis is straightforward due to temporal relationship between agent and resultant eruption
- diagnosis of chronic contact stomatitis is more difficult, requirring good oral health and elimination of all other possible causes
What is the treatment and prognosis for allergic contact stomatitis?
- for mild acute cases, simply removal of suspected allergen
- for severe acute cases, antihistamines and topical anesthetics
- for chronic cases, topical corticosteroid gel or oral suspension
- use of plain baking soda or flavor-free toothpaste
- avoidance of mouthwash, gum, mints, chocolate, cinnamon products
Clinical Features
- associated with use of potent corticosteroids on face
- worsened by exposure to UV light, heat, and wind
- persistent erythematous papules, vesicles, and pustules
- occur on skin surrounding the vermilion border
- may involve perinasal skin (40%)
- zone of spared skin adjacent to vermilion border
- most occurs in women between ages of 20 to 45 years
Histopathologic Findings
- chronic lymphohistiocytic dermatitis with spongiosis of hair follicles
- rosacea-like pattern with perifollicular granulomatous inflammation
- may be misdiagnosed as sarcoidosis
perioral dermatitis

Multiple erythematous papules of the skin surrounding the vermilion border of the lips. Note similar involvement around the nasal orifices.
perioral dermatitis
What is the treatment for perioral dermatitis?
- discontinue corticosteroids, cosmetics, facial creams (“zero therapy”)
- oral tetracycline is "gold standard," except in childhood and pregnancy
- responds well to topical pimecrolimus or topical erythromycin
- improvement within weeks, resolution in months, recurrence uncommon
Clinical Features
- associated with candy, chewing gum, and toothpaste
- pain and burning are common in all cases
- affects gingiva, buccal mucosa, lateral borders of tongue
- may resemble plasma cell gingivitis
- enlargement, edema, and erythema
- hyperkeratosis of surface epithelium
Histopathologic Findings
- acanthotic, often with elongated rete ridges
- thinning of the suprapapillary plates
- hyperkeratosis and extensive neutrophilic exocytosis
- heavy inflammatory cell infiltrate
contact stomatitis from cinnamon flavoring

Oblong area of sensitive erythema with overlying shaggy hyperkeratosis. Buccal mucosal lesions often are aligned along the occlusal plane.
contact stomatitis from cinnamon flavoring

Sensitive and thickened hyperkeratosis of the lateral and dorsal surface of the tongue on the right side.
contact stomatitis from cinnamon flavoring

Left lateral border of the tongue demonstrating linear rows of hyperkeratosis that resemble oral hairy leukoplakia (OHL).
contact stomatitis from cinnamon flavoring

Oral mucosa demonstrating significant interface mucositis and deeper perivascular inflammation. Heavy inflammatory cell infiltrate often obscures the epithelium and connective tissue interface.
contact stomatitis from cinnamon flavoring

Perivascular inflammatory infiltrate consisting predominantly of lymphocytes and plasma cells, a characteristic feature in localized cases.
contact stomatitis from cinnamon flavoring
How is contact stomatitis from cinnamon flavoring diagnosed?
Based on the clinical appearance and the history of cinnamon use; often biopsies are performed for atypical or extensive cases.
What is the treatment and prognosis for contact stomatitis from cinnamon flavoring?
- disappears within 1 week of discontinuation of cinnamon product
- patient may benefit from short-term use of a topical corticosteroid
The vast majority of hypersensitivity reactions to dental restorative materials are to dental amalgam. What component is largely responsible?
mercury
Although rare acute reactions to mercury may be seen following placement of amalgam, the vast majority of adverse alterations are associated with older and corroded amalgams. What type of hypersensitivity reactions are these?
type IV hypersensitivity reaction
Clinical Features
- associated with dental restorations
- can be acute (rare) or chronic
- buccal mucosa and ventrolateral tongue
- white or erythematous, with or without peripheral striae
- no symptoms, but periodic erosion may be noted
Histopathologic Findings
- numerous features of lichen planus
- hyperkeratotic, atrophic, or ulcerated surface epithelium
- hydropic degeneration of basal cell layer
- dense bandlike chronic inflammatory cellular infiltrate
lichenoid contact reaction to dental restorative material

- Hyperkeratotic lesion with a peripheral radiating pattern on the lateral border of the tongue on the right side; the altered mucosa contacted the amalgams of the adjacent mandibular molar teeth.
- Appearance of previously altered area of the tongue 14 days after removal of adjacent amalgams. Note total resolution of the mucosal alterations.
lichenoid contact reaction to dental amalgam

Radiating pattern of hyperkeratotic striae on the posterior buccal mucosa that contacts a large distobuccal amalgam of the permanent mandibular second molar.
lichenoid contact reaction to dental amalgam
How is lichenoid contact reaction to dental amalgam diagnosed?
Based on (a) the clinical appearance of the lesion, (b) the lack of lesional migration, and (c) the correlation to adjacent dental metal.
What is the treatment and prognosis for lichenoid contact reaction to dental amalgam?
- acute reactions are self-limiting and resolve within 2 to 3 days
- for chronic reactions, local measures should be attempted first
- if unsuccessful, the amalgam in question should be replaced
A diffuse edematous swelling of the soft tissues, which has also been referred to historically as Quincke disease.
angioedema
Angioedema is a diffuse edematous swelling of the soft tissues. What are the potential causes of angioedema?
- allergic IgE-mediated hypersensitivity reactions
- angiotensin-converting enzyme (ACE) inhibitors
- hereditary—type I (C1-INH deficiency) or type II (C1-INH dysfunction)
- acquired—lymphoproliferative or autoimmune
An unusual pattern of drug reaction that can produce severe forms of angioedema that are not mediated by IgE is the type associated with ACE inhibitors. What is thought to be the cause of this reaction?
excess bradykinin (ACE degrades bradykinin)
Clinical Features
- rapid onset of soft, nontender tissue swelling
- may be solitary or multiple
- extremities most common cutaneous sites
- edema of larynx, pharynx, uvula, or soft palate
- deeper voice, hoarseness, aphonia, and dyspnea
- pain is unusual, but itching is common
- typically resolves over 24 to 72 hours
- drug-associated form more common in blacks
angioedema

Diffuse upper lip swelling that arose rapidly.
angioedema

- A, Soft, nontender tissue swelling of the face arose relatively rapidly after dental treatment.
- Facial appearance after resolution of edematous facial enlargement.
angioedema
How is angioedema diagnosed?
- for allergic causes, diagnosis is based on clinical presentation in conjunction with the known antigenic stimulus
- case unrelated to antigenic exposure or medications should be
evaluated for the presence of adequate functional C1-INH:
- type I hereditary—normal C1, low C1-INH
- type II hereditary—normal C1, normal C1-INH
- lymphoproliferative—low C1, low C1-INH
- autoimmune—low C1, normal C1-INH
What is the treatment and prognosis for angioedema?
- oral antihistamines, IM epinephrine, IV corticosteroids
- discontinue ACE inhibitors